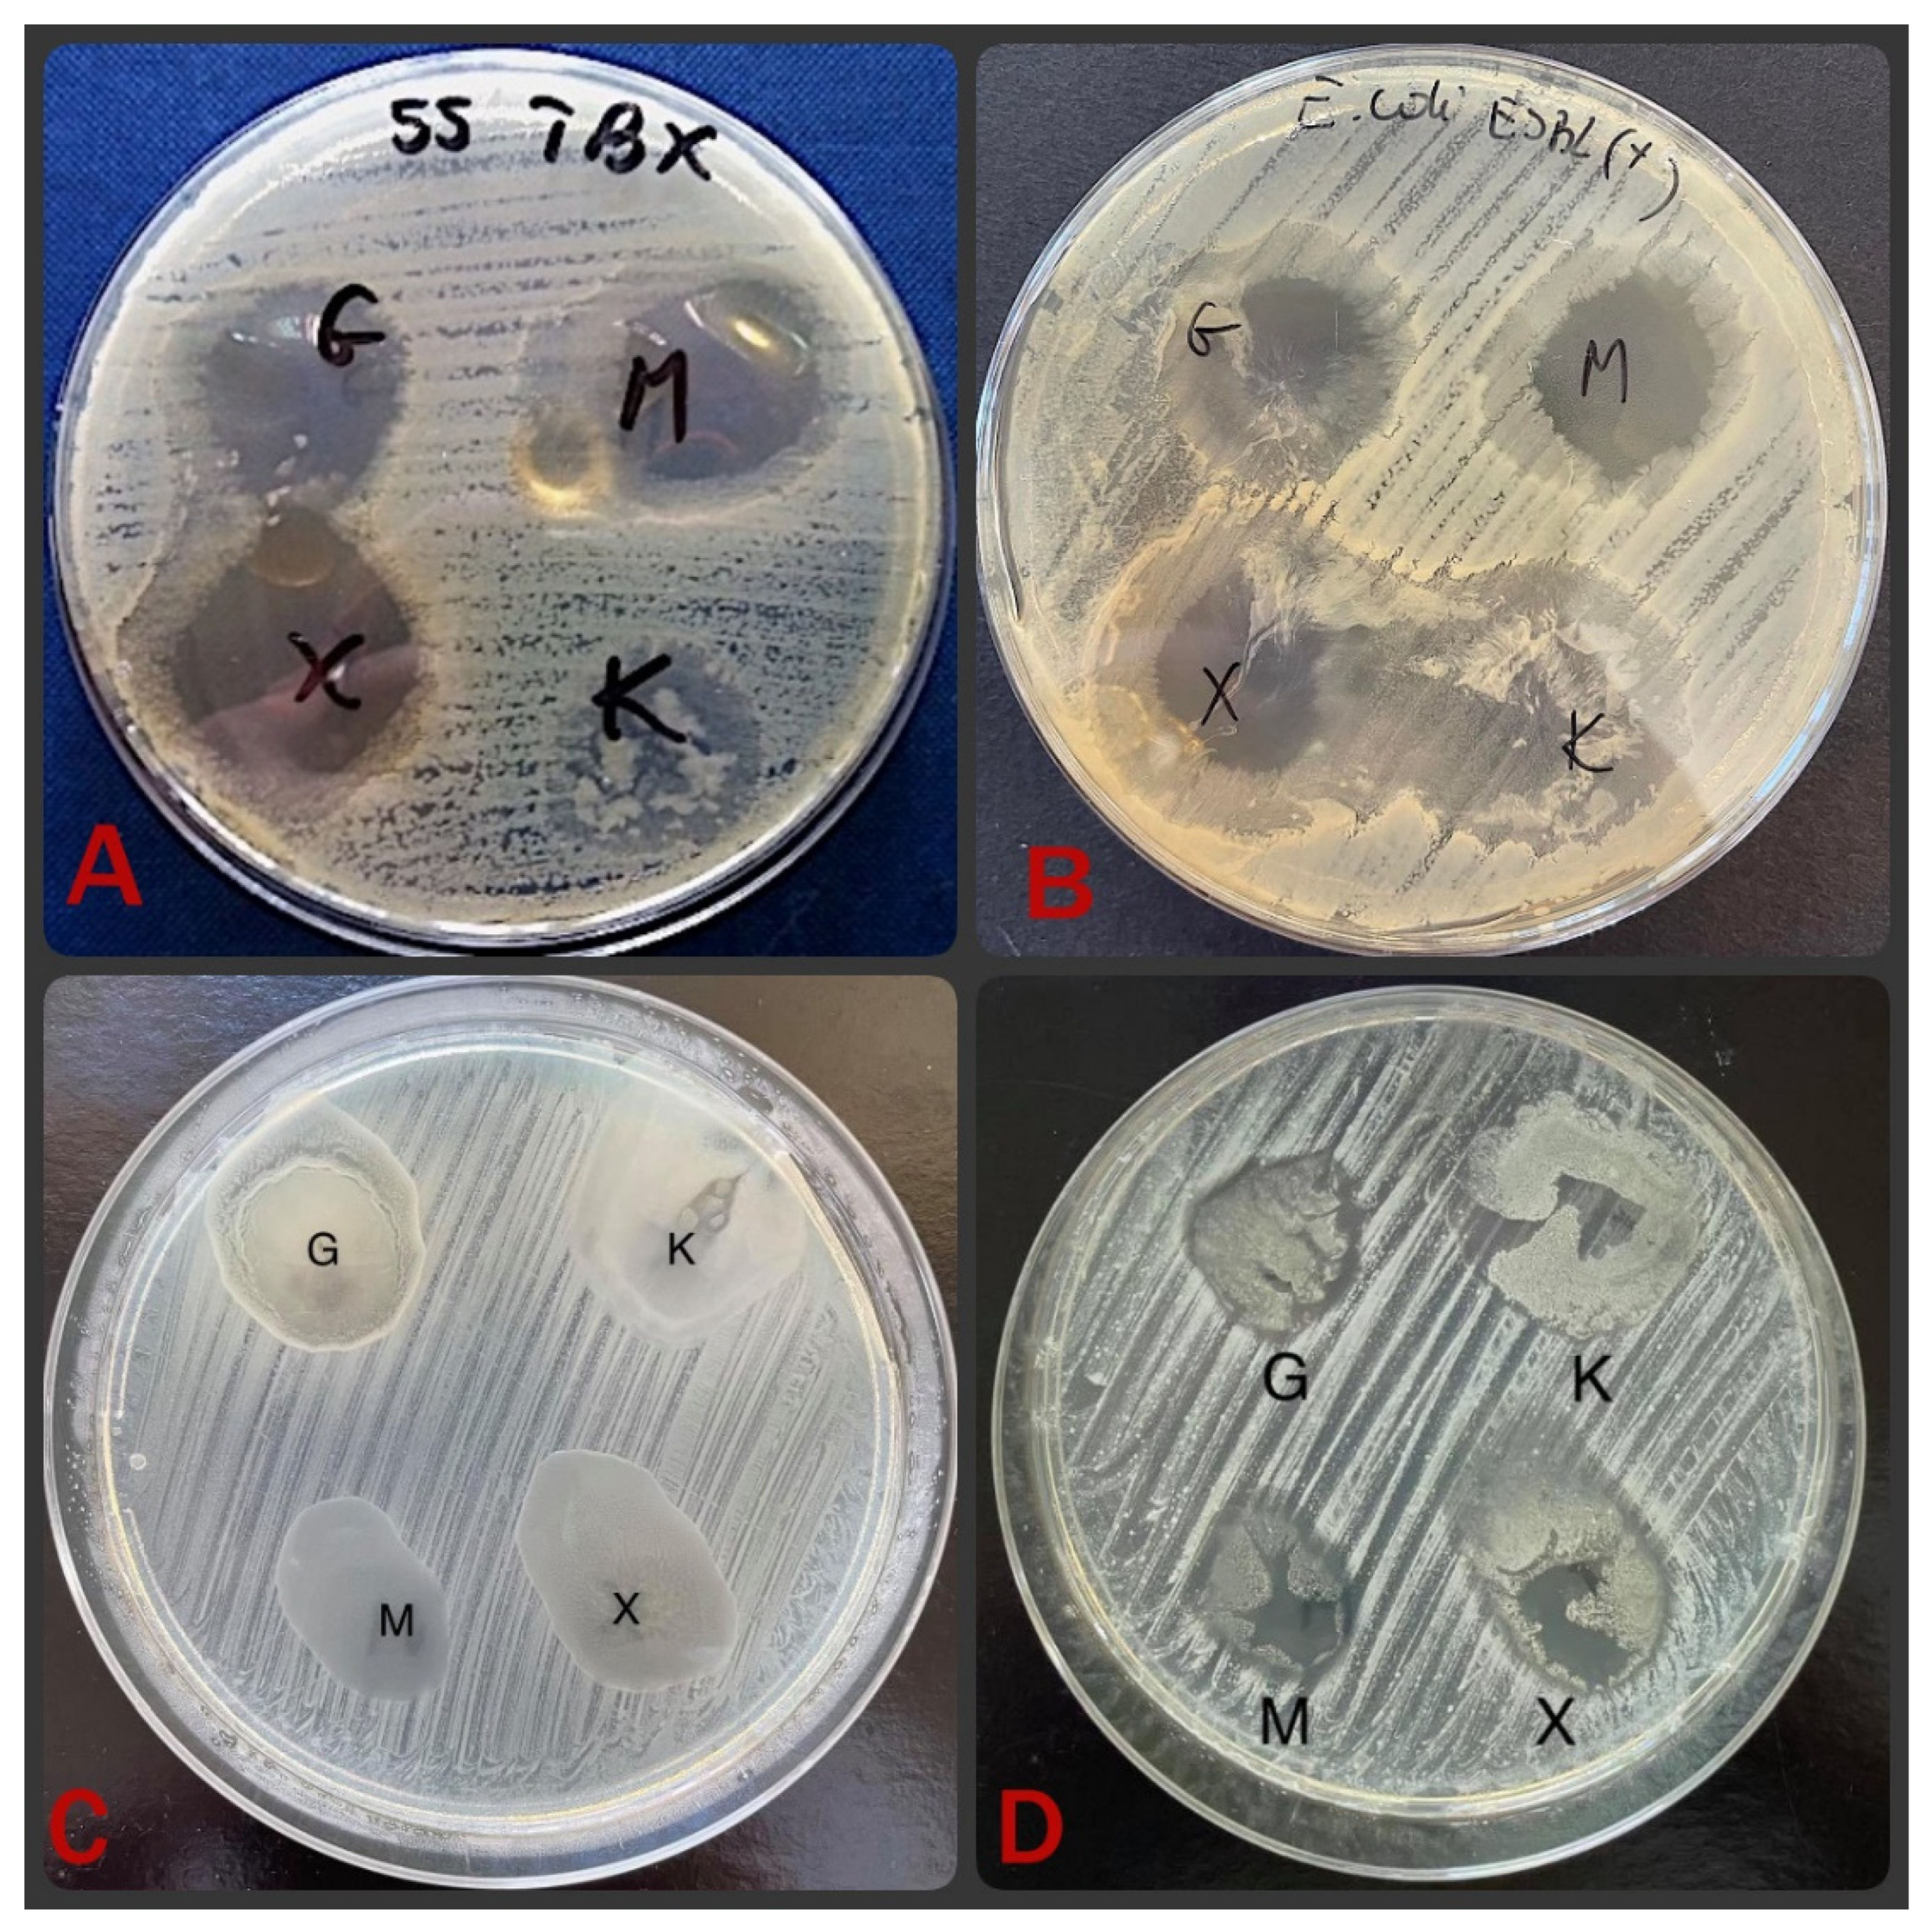
Materials 15 01269 g005

Antibacterial Properties of Biodegradable Silver Nanoparticle Foils Based on Various Strains of Pathogenic Bacteria Isolated from the Oral Cavity of Cats, Dogs and Horses
Abstract
1. Introduction
2. Materials and Methods
2.1. Materials
2.2. Synthesis of Alginate Films Containing Silver Nanoparticles
2.3. Fourier Transform Infrared (FTIR) Spectroscopy
2.4. Ultraviolet-Visible (UV-VIS) Spectrometry
2.5. Scanning Electron Microscopy (SEM)
2.6. Isolation and Identification of Bacteria from Cats, Dogs and Horses
2.7. Evaluation of Antibacterial Activity of Nanosilver-Containing Foils
2.8. Statistical Analysis
- (a)
- the significance of differences between the antibacterial activity of various types of foils;
- (b)
- the significance of differences between the activity of foils against microorganisms isolated from various groups of animals;
- (c)
- the significance of differences in the activity of foils against Gram-positive and Gram-negative bacteria;
- (d)
- the significance of differences in the activity of foils against bacteria belonging to different species/groups.
3. Results and Discussion
3.1. Physicochemical Properties of Biodegradable Foils
3.2. Isolation and Identification of Bacterial Pathogens and Opportunistic Pathogens from Animals
3.3. Antibacterial Effect of Nanosilver Foils
4. Conclusions
Supplementary Materials
Author Contributions
Funding
Institutional Review Board Statement
Informed Consent Statement
Data Availability Statement
Conflicts of Interest
References
- Lashin, I.; Fouda, A.; Gobouri, A.A.; Azab, E.; Mohammedsaleh, Z.M.; Makharita, R.R. Antimicrobial and in vitro cytotoxic efficacy of biogenic silver nanoparticles (ag-nps) fabricated by callus extract of Solanum incanum L. Biomolecules 2021, 11, 341. [Google Scholar] [PubMed]
- Parisi, C.; Vigani, M.; Rodríguez-Cerezo, E. Agricultural nanotechnologies: What are the current possibilities? Nano Today 2015, 10, 124–127. [Google Scholar] [CrossRef]
- Jurkow, R.; Pokluda, R.; Sękara, A.; Kalisz, A. Impact of foliar application of some metal nanoparticles on antioxidant system in oakleaf lettuce seedlings. BMC Plant Biol. 2020, 20, 290. [Google Scholar] [CrossRef] [PubMed]
- Nile, S.H.; Baskar, V.; Selvaraj, D.; Nile, A.; Xiao, J.; Kai, G. Nanotechnologies in food science: Applications, recent trends, and future perspectives. Nanomicro Lett. 2020, 12, 45. [Google Scholar] [CrossRef]
- Sastry, M.; Ahmad, A.; Khan, M.I.; Kumar, R. Biosynthesis of metal nanoparticles using fungi and actinomycete. Curr. Sci. 2003, 85, 162–170. [Google Scholar]
- Iravani, S. Green synthesis of metal nanoparticles using plants. Green Chem. 2011, 13, 2638–2650. [Google Scholar] [CrossRef]
- Wiley, B.; Sun, Y.; Mayers, B.; Xia, Y. Shape-controlled synthesis of metal nanostructures: The case of silver. Chemistry 2005, 11, 454–463. [Google Scholar] [CrossRef]
- Yin, I.X.; Zhang, J.; Zhao, I.S.; Mei, M.L.; Li, Q.; Chu, C.H. The antibacterial mechanism of silver nanoparticles and its application in dentistry. Int. J. Nanomed. 2020, 15, 2555–2562. [Google Scholar]
- Morales-Avila, E.; Ferro-Flores, G.; Ocampo-García, B.E.; López-Téllez, G.; López-Ortega, J.; Rogel-Ayala, D.G.; Sánchez-Padilla, D. Antibacterial efficacy of gold and silver nanoparticles functionalized with the ubiquicidin (29–41) antimicrobial peptide. J. Nanomater. 2017, 2017, 5831959. [Google Scholar] [CrossRef]
- Franci, G.; Falanga, A.; Galdiero, S.; Palomba, L.; Rai, M.; Morelli, G.; Galdiero, M. Silver nanoparticles as potential antibacterial agents. Molecules 2015, 20, 8856–8874. [Google Scholar] [CrossRef]
- Bykkam, S.; Narsingam, S.; Ahmadipour, M.; Dayakar, T.; Venkateswara Rao, K.; Shilpa Chakra, C.; Kalakotla, S. Few layered graphene sheet decorated by ZnO nanoparticles for anti-bacterial application. Superlattices Microstruct. 2015, 83, 776–784. [Google Scholar] [CrossRef]
- Zhou, Y.; Kong, Y.; Kundu, S.; Cirillo, J.D.; Liang, H. Antibacterial activities of gold and silver nanoparticles against Escherichia coli and Bacillus Calmette-Guérin. J. Nanobiotechnol. 2012, 10, 19. [Google Scholar] [CrossRef] [PubMed]
- Cumpstey, I. Chemical modification of polysaccharides. Int. Sch. Res. Not. 2013, 27. [Google Scholar] [CrossRef] [PubMed]
- Li, S.; Xiong, Q.; Lai, X.; Li, X.; Wan, M.; Zhang, J.; Yan, Y.; Cao, M.; Lu, L.; Guan, J.; et al. Molecular modification of polysaccharides and resulting bioactivities. Compr. Rev. Food Sci. Food Saf. 2016, 15, 237–250. [Google Scholar] [CrossRef] [PubMed]
- Chernikov, O.V.; Chiu, H.-W.; Li, L.-H.; Kokoulin, M.S.; Molchanova, V.I.; Hsu, H.-T.; Ho, C.-L.; Hua, K.-F. Immunomodulatory Properties of Polysaccharides from the Coral Pseudopterogorgia americana in Macrophages. Cells 2021, 10, 3531. [Google Scholar] [CrossRef] [PubMed]
- Lin, W.; Mashiah, R.; Seror, J.; Kadar, A.; Dolkart, O.; Pritsch, T.; Goldberg, R.; Klein, J. Lipid-hyaluronan synergy strongly reduces intrasynovial tissue boundary friction. Acta Biomater. 2019, 83, 314–321. [Google Scholar] [CrossRef]
- Darder, M.; Aranda, P.; Ruiz-Hitzky, E. Bionanocomposites: A new concept of ecological, bioinspired, and functional hybrid materials. Adv. Mater. 2007, 19, 1309–1319. [Google Scholar] [CrossRef]
- Dias, A.M.G.C.; Hussain, A.; Marcos, A.S.; Roque, A.C.A. A biotechnological perspective on the application of iron oxide magnetic colloids modified with polysaccharides. Biotechnol. Adv. 2011, 29, 142–155. [Google Scholar] [CrossRef]
- Hanemann, T.; Szabó, D.V. Polymer-nanoparticle composites: From synthesis to modern applications. Materials 2010, 3, 3468–3517. [Google Scholar] [CrossRef]
- Emam, H.E.; Ahmed, H.B. Polysaccharides templates for assembly of nanosilver. Carbohydr. Polym. 2016, 135, 300–307. [Google Scholar] [CrossRef]
- Norajit, K.; Kim, K.M.; Ryu, G.H. Comparative studies on the characterization and antioxidant properties of biodegradable alginate films containing ginseng extract. J. Food Eng. 2010, 98, 377–384. [Google Scholar] [CrossRef]
- Abdollahi, M.; Alboofetileh, M.; Rezaei, M.; Behrooz, R. Comparing physico-mechanical and thermal properties of alginate nanocomposite films reinforced with organic and/or inorganic nanofillers. Food Hydrocoll. 2013, 32, 416–424. [Google Scholar] [CrossRef]
- Huq, T.; Salmieri, S.; Khan, A.; Khan, R.A.; Le Tien, C.; Riedl, B.; Fraschini, C.; Bouchard, J.; Uribe-Calderon, J.; Kamal, M.R.; et al. Nanocrystalline cellulose (NCC) reinforced alginate based biodegradable nanocomposite film. Carbohydr. Polym. 2012, 90, 1757–1763. [Google Scholar] [CrossRef] [PubMed]
- Martí, M.; Frígols, B.; Salesa, B.; Serrano-Aroca, Á. Calcium alginate/graphene oxide films: Reinforced composites able to prevent Staphylococcus aureus and methicillin-resistant Staphylococcus epidermidis infections with no cytotoxicity for human keratinocyte HaCaT cells. Eur. Polym. J. 2019, 110, 14–21. [Google Scholar] [CrossRef]
- Batista, P.S.P.; de Morais, A.M.M.B.; Pintado, M.M.E.; de Morais, R.M.S.C. Alginate: Pharmaceutical and medical applications. In Extracellular Sugar-Based Biopolymers Matrices; Cohen, E., Merzendorfer, H., Eds.; (Biologically-Inspired Systems); Springer: Cham, Switzerland, 2019; pp. 649–691. [Google Scholar]
- Rowson, J.; Sangrar, A.; Rodriguez-Falcon, E.; Bell, A.; Walton, K.; Yoxall, A.; Kamat, S. Rating accesability of packaging: A medical packaging example. Packag. Technol. Sci. 2016, 29, 607. [Google Scholar] [CrossRef]
- Septianto, F.; Lee, M.S. Emotional responses to plastic waste: Matching image and message framing in encouraging consumers to reduce plastic consumption. Australas. Mark. J. 2019, 28, 18–29. [Google Scholar] [CrossRef]
- Robinson, N.J.; Dean, R.S.; Cobb, M.; Brennan, M.L. Factors influencing common diagnoses made during first-opinion small-animal consultations in the United Kingdom. Prev. Vet. Med. 2016, 131, 87–94. [Google Scholar] [CrossRef]
- Van Dyke, T.E.; Sheilesh, D. Risk factors for periodontitis. J. Int. Acad. Periodontol. 2005, 7, 3–71. [Google Scholar]
- Boost, M.V.; O’Donoghue, M.M.; James, A. Prevalence of Staphylococcus aureus carriage among dogs and their owners. Epidemiol. Infect. 2008, 136, 953–964. [Google Scholar] [CrossRef]
- Bierowiec, K.; Płoneczka-Janeczko, K.; Rypuła, K. Is the Colonisation of Staphylococcus aureus in pets associated with their close contact with owners? PLoS ONE 2016, 11, e0156052. [Google Scholar] [CrossRef]
- Moodley, A.; Nightingale, E.C.; Nielsen, S.S.; Skov, R.L.; Guardabassi, L. High risk for nasal carriage of methicillin-resistant Staphylococcus aureus among Danish veterinary practitioners. Scand. J. Work Environ. Health 2008, 34, 151–157. [Google Scholar] [CrossRef][Green Version]
- Wertheim, H.F.; Melles, D.C.; Vos, M.C.; van Leeuwen, W.; van Belkum, A.; Verbrugh, H.A.; Nouwen, J.L. The role of nasal carriage in Staphylococcus aureus infections. Lancet Infect. Dis. 2005, 5, 751–762. [Google Scholar] [CrossRef]
- Nowak, N.; Grzebieniarz, W.; Khachatryan, G.; Khachatryan, K.; Konieczna-Molenda, A.; Krzan, M.; Grzyb, J. Synthesis of silver and gold nanoparticles in sodium alginate matrix enriched with graphene oxide and investigation of properties of the obtained thin films. Appl. Sci. 2021, 11, 3857. [Google Scholar] [CrossRef]
- Wei, L.; Lu, J.; Xu, H.; Patel, A.; Chen, Z.S.; Chen, G. Silver nanoparticles: Synthesis, properties, and therapeutic applications. Drug Discov. Today 2015, 20, 595–601. [Google Scholar] [CrossRef] [PubMed]
- Li, W.R.; Xie, X.B.; Shi, Q.S.; Zeng, H.Y.; You-Sheng, O.Y.; Chen, Y.B. Antibacterial activity and mechanism of silver nanoparticles on Escherichia coli. Appl. Microbiol. Biotechnol. 2010, 85, 1115–1122. [Google Scholar] [CrossRef]
- Bahlol, H.S.; Foda, M.F.; Ma, J.; Han, H. Robust synthesis of size-dispersal triangular silver nanoprisms via chemical reduction route and their cytotoxicity. Nanomaterials 2019, 9, 674. [Google Scholar] [CrossRef]
- Filippo, E.; Serra, A.; Buccolieri, A.; Manno, D. Green synthesis of silver nanoparticles with sucrose and maltose: Morphological and structural characterization. J. Non Cryst. Solids 2010, 356, 344–350. [Google Scholar] [CrossRef]
- Chunfa, D.; Xianglin, Z.; Hao, C.; Chuanliang, C. Sodium alginate mediated route for the synthesis of monodisperse silver nanoparticles using glucose as reducing agents. Rare Metal Mater. Eng. 2016, 45, 261–266. [Google Scholar] [CrossRef]
- Khachatryan, G.; Khachatryan, K.; Krystyjan, M.; Krzan, M.; Khachatryan, L. Functional properties of composites containing silver nanoparticles embedded in hyaluronan and hyaluronan-lecithin matrix. Int. J. Biol. Macromol. 2020, 149, 417–423. [Google Scholar] [CrossRef]
- Nalini, T.; Basha, S.K.; Sadiq, A.M.M.; Kumari, V.S.; Kaviyarasu, K. Development and characterization of alginate/chitosan nanoparticulate system for hydrophobic drug encapsulation. J. Drug Deliv. Sci. Technol. 2019, 52, 65–72. [Google Scholar] [CrossRef]
- Burton, S.; Reid-Smith, R.; McClure, J.T.; Weese, J.S. Staphylococcus aureus colonization in healthy horses in Atlantic Canada. Can. Vet. J. 2008, 49, 797–799. [Google Scholar] [PubMed]
- Gergeleit, H.; Verspohl, J.; Rohde, J.; Rohn, K.; Ohnesorge, B.; Bienert-Zeit, A. A prospective study on the microbiological examination of secretions from the paranasal sinuses in horses in health and disease. Acta Vet. Scand. 2018, 60, 43. [Google Scholar] [CrossRef] [PubMed]
- Neradova, K.; Jakubu, V.; Pomorska, K.; Zemlickova, H. Methicillin-resistant Staphylococcus aureus in veterinary professionals in 2017 in the Czech Republic. BMC Vet. Res. 2020, 16, 4. [Google Scholar] [CrossRef] [PubMed]
- Middleton, J.R.; Fales, W.H.; Luby, C.D.; Oaks, J.L.; Sanchez, S.; Kinyon, J.M.; Wu, C.C.; Maddox, C.W.; Welsh, R.D.; Hartmann, F. Surveillance of Staphylococcus aureus in veterinary teaching hospitals. J. Clin. Microbiol. 2005, 43, 2916–2919. [Google Scholar] [CrossRef] [PubMed]
- Polkowska, I.; Sobczyńska-Rak, A.; Gołyńska, M. Analysis of gingival pocket microflora and biochemical blood parameters in dogs suffering from periodontal disease. In Vivo 2014, 28, 1085–1090. [Google Scholar] [PubMed]
- Loo, Y.Y.; Rukayadi, Y.; Nor-Khaizura, M.A.R.; Kuan, C.H.; Chieng, B.W.; Nishibuchi, M.; Radu, S. In Vitro antimicrobial activity of green synthesized silver nanoparticles against selected Gram-negative foodborne pathogens. Front. Microbiol. 2018, 9, 1555. [Google Scholar] [CrossRef] [PubMed]
- Rubin, J.E.; Ball, K.R.; Chirino-Trejo, M. Antimicrobial susceptibility of Staphylococcus aureus and Staphylococcus pseudintermedius isolated from various animals. Can. Vet. J. 2011, 52, 153–157. [Google Scholar]
- Al-Sharqi, A.; Apun, K.; Vincent, M.; Kanakaraju, D.; Bilung, L.M. Enhancement of the antibacterial efficiency of silver nanoparticles against Gram-positive and Gram-negative bacteria using blue laser light. Int. J. Photoenergy 2019, 2019, 2528490. [Google Scholar] [CrossRef]
- McNeilly, O.; Mann, R.; Hamidian, M.; Gunawan, C. Emerging concern for silver nanoparticle resistance in Acinetobacter baumannii and other bacteria. Front. Microbiol. 2021, 12, 652863. [Google Scholar] [CrossRef]

| Bacterial Species/Groups | Cats | Dogs | Horses | Type Species |
|---|---|---|---|---|
| S. aureus | 21 | 21 | 1 | S. aureus ATCC 29213 (susceptible) |
| MRSA | 4 | 2 | 0 | S. aureus NCTC 12493 |
| E. coli | 0 | 0 | 15 | E. coli ATCC 35218E. coli ATCC 25922 |
| ESBL | 3 | 1 | 6 | E. coli ESBL (+) UTI |
| Total | 28 | 24 | 22 | 5 |
| Animals | Bacteria | AgNP Foils | ||
|---|---|---|---|---|
| Maltose | Xylose | Glucose | ||
| cats | S. aureus | 57.14 | 66.67 | 71.43 |
| MRSA | 100.00 | 100.00 | 100.00 | |
| ESBL | 16.67 | 33.33 | 33.33 | |
| dogs | S. aureus | 85.71 | 61.90 | 80.95 |
| MRSA | 100.00 | 100.00 | 0.00 | |
| ESBL | 100.00 | 100.00 | 0.00 | |
| horses | S. aureus | 0.00 | 100.00 | 100.00 |
| E. coli | 73.33 | 86.67 | 73.33 | |
| ESBL | 75.00 | 83.33 | 75.00 | |
| total | S. aureus | 70.59 | 64.71 | 76.47 |
| MRSA | 100.00 | 100.00 | 50.00 | |
| E. coli | 60.00 | 70.00 | 55.00 | |
| ESBL | 70.59 | 64.71 | 76.47 | |
| Groups of Bacteria | Tested Foils | ||||
|---|---|---|---|---|---|
| Type of Foil | Ag-Maltose | Ag-Xylose | Ag-Glucose | Control | |
| S. aureus H = 109.53 p = 0.000 | Ag-maltose | - | 0.89/1.00 | 0.32/1.00 | 8.21/0.000 |
| Ag-xylose | 0.89/1.00 | - | 1.22/1.00 | 7.66/0.000 | |
| Ag-glucose | 0.32/1.00 | 1.22/1.00 | - | 8.52/0.000 | |
| Control | 8.21/0.000 | 7.66/0.000 | 8.52/0.000 | - | |
| MRSA H = 16.99 p = 0.0007 | Ag-maltose | - | 0.51/1.00 | 1.92/0.790 | 3.65/0.006 |
| Ag-xylose | 0.51/1.00 | - | 1.41/1.00 | 3.14/0.007 | |
| Ag-glucose | 1.92/1.00 | 1.41/1.00 | - | 1.73/1.00 | |
| Control | 3.65/0.009 | 3.14/0.007 | 1.73/1.00 | - | |
| E. coli H = 21.69 p = 0.0001 | Ag-maltose | - | 1.58/0.691 | 0.28/1.00 | 4.76/0.000 |
| Ag-xylose | 1.58/0.691 | - | 1.30/1.00 | 6.34/0.000 | |
| Ag-glucose | 0.28/1.00 | 1.30/1.00 | - | 5.04/0.000 | |
| Control | 4.76/0.000 | 6.34/0.000 | 5.04/0.030 | - | |
| ESBL H = 50.13 p = 0.000 | Ag-maltose | - | 0.59/1.00 | 0.59/1.00 | 3.36/0.005 |
| Ag-xylose | 0.59/1.00 | - | 1.18/1.00 | 3.95/0.000 | |
| Ag-glucose | 0.59/1.00 | 1.18/1.00 | - | 2.77/0.034 | |
| Control | 3.36/0.005 | 3.95/0.000 | 2.77/0.034 | - | |
Publisher’s Note: MDPI stays neutral with regard to jurisdictional claims in published maps and institutional affiliations. |
© 2022 by the authors. Licensee MDPI, Basel, Switzerland. This article is an open access article distributed under the terms and conditions of the Creative Commons Attribution (CC BY) license (https://creativecommons.org/licenses/by/4.0/).
Share and Cite
Rutkowski, M.; Krzemińska-Fiedorowicz, L.; Khachatryan, G.; Kabacińska, J.; Tischner, M.; Suder, A.; Kulik, K.; Lenart-Boroń, A. Antibacterial Properties of Biodegradable Silver Nanoparticle Foils Based on Various Strains of Pathogenic Bacteria Isolated from the Oral Cavity of Cats, Dogs and Horses. Materials 2022, 15, 1269. https://doi.org/10.3390/ma15031269
Rutkowski M, Krzemińska-Fiedorowicz L, Khachatryan G, Kabacińska J, Tischner M, Suder A, Kulik K, Lenart-Boroń A. Antibacterial Properties of Biodegradable Silver Nanoparticle Foils Based on Various Strains of Pathogenic Bacteria Isolated from the Oral Cavity of Cats, Dogs and Horses. Materials. 2022; 15(3):1269. https://doi.org/10.3390/ma15031269
Chicago/Turabian StyleRutkowski, Miłosz, Lidia Krzemińska-Fiedorowicz, Gohar Khachatryan, Julia Kabacińska, Marek Tischner, Aleksandra Suder, Klaudia Kulik, and Anna Lenart-Boroń. 2022. "Antibacterial Properties of Biodegradable Silver Nanoparticle Foils Based on Various Strains of Pathogenic Bacteria Isolated from the Oral Cavity of Cats, Dogs and Horses" Materials 15, no. 3: 1269. https://doi.org/10.3390/ma15031269
APA StyleRutkowski, M., Krzemińska-Fiedorowicz, L., Khachatryan, G., Kabacińska, J., Tischner, M., Suder, A., Kulik, K., & Lenart-Boroń, A. (2022). Antibacterial Properties of Biodegradable Silver Nanoparticle Foils Based on Various Strains of Pathogenic Bacteria Isolated from the Oral Cavity of Cats, Dogs and Horses. Materials, 15(3), 1269. https://doi.org/10.3390/ma15031269

